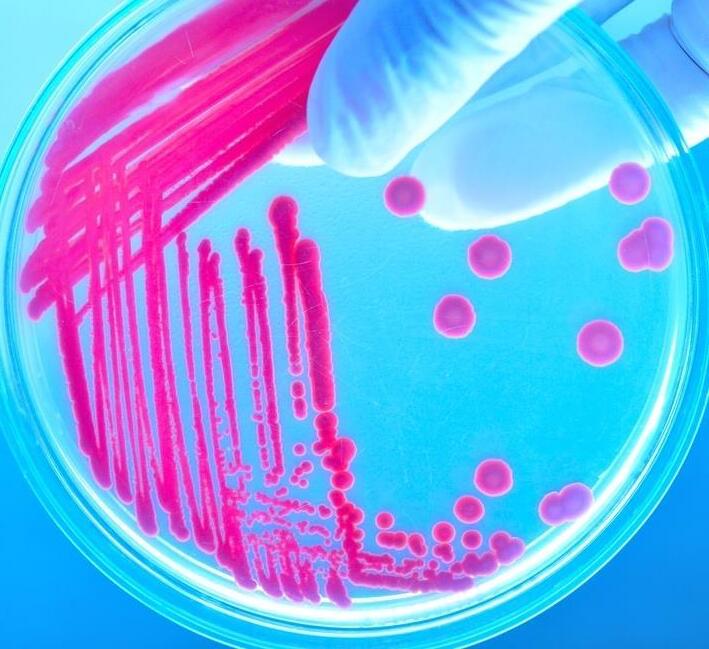

Webinar will start at 3pm (GMT) 8 October
![]()


Webinar will start at 3pm (GMT) 8 October

Dr Bev Isherwood

Dr Bev Isherwood




paceamr.org.uk

Bring together the sector to help innovators with early-stage antimicrobial and diagnostics projects move forward with greater speed and confidence, accelerating the delivery of new innovations to tackleAMR

Where we fit in the
The (inter)national context

Basic Research Concept Studies Development From lab….. ….to launch

Nurturing innovation
✓ Early-Stage Funding
✓ Support to create de-risked investable propositions
✓ Access to infrastructure & expertise
✓ Developing entrepreneurial talent

New small molecule antibacterial drugs launched from January 2000 to December 2022

REF: Butler et al. J Antibiot 76, 431–473 (2023). https://\\doi.org/10.1038/s41429-023-00629-8

*Global AMR R&DHub Dynamic Dashboard data July 2025 ** Global burden of bacterial antimicrobial resistance 1990–2021: a systematic analysis with forecasts to 2050
There is a lack of novelty in the clinical pipeline




REF: WHO (2024). Global Observatory on Health R&D, accessed June 2024
>80% of preclinical projects are being conducted by SMEs & academics

REF: WHO (2024). 2023 Antibacterial agents in clinical and preclinical development: an overview and analysis

Empowering Innovation: Accelerating Early Translation
Strengthening
Grow a pipeline aligned with unmet needs & routes to market
Enabling Collaborative support to build de-risked investment ready assets
Accelerating
Enabling capabilities to advance the portfolio & bring sector benefit
The right funding, at the right time with the right support
PACE funding is highly strategic, centred on addressing critical unmet needs:

• Innovative and differentiated antimicrobials1
• Diagnostic innovations with health & health system benefits2
Innovation Assessment of the 2023 Antibacterial Pipeline
Only 6 of the 32 clinical stage antibacterials targeting WHO priority pathogens meet at least 3 of the innovation criteria – more are urgently needed.
Antimicrobial Resistance and Diagnostics
Appropriate and rapid diagnostics to indicate which antibiotic should be used & reduce inappropriate antibiotic prescriptions are urgently needed.




PACE aims to drive tangible progress on this pipeline.



1WHO Priority Pathogens & GBD2021
2Unmet needs inAMR diagnostics

• Funding rounds to attract high-potential innovators globally in academia and biotech.
• Two-stage selection with intensive 2nd-phase Catalyser: 10-week structured support for shortlisted projects –focused on refining clinical positioning, feasibility/workplan & full application submission.
• Rigorous selection, external panel evaluation & involvement of people affected by AMR.
• Projects actively managed, milestone based nondilutive funding of up to £1m per project.
• Therapeutics progressed through Hit-to-Lead and Lead Optimisation & Diagnostics through TRL3-5.
Structured support to provide the critical ‘non-funding’ inputs required to catalyse & better enable asset progression:

Embedding real-world use into asset design and progression
Funders & investors
Industry & trade bodies

Mentors & advisors
Understanding & navigating endend R&D process
Timely access to required scientific capability for decision-grade data
Academia

CROs & UK infrastructure

Acceleration & Innovation AMR
Regulators, payers & HTA bodies
Patients, charities, advocacy groups Delivery Partner Network



Delivered through partnering across the sector. Developed resources also made available to the wider community.

11 Portfolio Projects
£11m committed
36 organisations supported through PACE Catalyser
2 Funding Rounds
348 projects assessed
Partnerships with UKHSA, VOCAL & a network of 20 delivery partners
Reports on Unmet Dx Needs & Tx Sector Needs
Programme established
A new national centre aimed at translation new source of sector funding & support
Revitalised national mission for R&D of novel Tx & Dx
Strengthened pipeline with more investment ready assets

Better ability to tackle AMR through increased international collaboration & enhanced capability


PACE’s third funding round;
focused on developing new antibacterial treatments for the most threatening microbes and resistance mechanisms
Aim to provide participants with funding and support that secures delivery of key data for onward development and investment
Up to £1M per project & 2 years in length
Innovative, higher risk projects of smaller scales are highly encouraged to apply
The portfolio will be actively managed. Projects will receive support and advice from the PACE team

PACE funding call focus Target
Therapeutics for drug-resistant Gram-negative bacterial infections
Phase Hit-to-Lead, Lead Optimisation
Intervention type Novel MoA, target and/ or new chemical class, and no observed cross resistance; including direct-acting and non-direct acting
Modality Agnostic (but must have antimicrobial effect)
Indications Drug-resistant LRTI, BSI, cUTI
Pathogens
Bacterial species associated with highest-burden indications aligned to GRAM report and WHO BPPL – inclusion of drugresistant priority Gram-negative bacteria essential (Ab, Ec, Kp and/ or Pa) – see preferred profiles for further details
Projects that are:
• Directed at drug-resistant bacteria associated with indications of highest burden of AMR based on theWHO priority list1 and Global burden studies2
• Transformational, with the aim to fill a gap for innovative & differentiated antimicrobials3 in the clinical pipeline
Preferred profiles for therapeutics targeting Gram-negative infections
Priority pathogens Ab, Ec, Kp and Pa Pa and/ or Kp essential. Other Enterobacterales and Ab preferred
Ec and Kp essential. Pm, Pa and other major cUTI pathogens preferred.

Spectrum
Any spectrum of activity (broad or narrow) but requirement, at a minimum, to cover priority pathogen(s) for the indication
Resistance
Activity against carbapenem and 3rd generation cephalosporin resistant strains (e.g. CRE, ESBL, CRAB, CRPA), low FoR, no cross resistance with standard of care antibiotics
Administration Oral and IV preferred. IV-only acceptable.* Oral, or IV and oral*
*Alternative routes of administration will be considered (e.g. inhaled for LRTI), with strong supporting rationale
*IV only not acceptable
1 https://www.who.int/publications/i/item/9789240093461 2

• Target identification, screening and hit identification
• Projects focused on late-stage pre-clinical/ IND-enabling studies
• Clinical Phase R&D
• Antibiotics based on iterations of existing therapeutics e.g., β-lactams
• Vaccines
• Interventions focussed exclusively on mycobacteria (including TB), fungal, low-priority Gram-negative or Gram-positive pathogens
• Therapeutics solely focussed on out-of-scope indications with no potential to pivot (e.g. topical treatments for skin infections)
• Projects not directly focused on antimicrobial development (e.g., diagnostics, delivery methods, biomarkers, standalone technology or model development) PACE funding call focus

• Researchers from academia or from SMEs worldwide, including consortia (large Pharma partners permitted, but must cover own costs)
• Applications should have a single identified lead applicant, however co-applicants are welcome
• Should last up to two years
• Will be milestone driven with clear go/ no-go progression criteria defined upfront
• With up to £1 million GBP of direct costs
• Innovative, higher risk projects of smaller scale are highly encouraged to apply

Our intention is not just to fund but to add additional support to enable the best chances of success for projects to attract further onward investment
Support throughout the project funding journey tailored to individual project needs, working in partnership with the PACE team:
✓ Support through the application process (e.g. 1:1s, advice on full application, Catalyser workshop)
✓ Drug discovery & disease area insight, advice & mentorship
✓ Access to a collaborative network of potential project delivery partners (PACE DPN)
✓ Access to a unique partnership with UKHSA for evaluation of in vitro antimicrobial activity
✓ Facilitate and support project delivery where applicable (e.g. development of statement of works and acting as point of contact with delivery partners)
✓ Facilitate scientific advisory boards, and public and patient engagement panels
✓ Business support (e.g. orientation to potential downstream funders, commercial know-how such as pitch-deck preparation)

Delivery Partner Network


For innovators to maximise impact & reach their potential, it is essential that funded recipients and the PACE team work closely together. Therefore, we have the following expectations of applicants & funded recipients:
✓ Be engaged in the process and work collaboratively with the PACE team, especially R&D advisors, in all aspects of project development and lifecycle if successful (note: our PACE R&D advisers are separated from funding governance and provide support not monitoring).
✓ Each applicant will, if successful, attend (or send a delegate) to the Catalyser workshop (virtual).
✓ Successfully funded projects to start within 3 months of the receipt of an award letter and be committed to the project length specified.
✓ Legal and ethical requirements are followed (e.g., award agreement terms, good research practice in conducting work).
✓ Applicant will highlight and raise any issues or concerns in a timely manner throughout the process.

Intellectual Property and Ownership of results
• Funding is non-dilutive
• Recipient background and arising IP will remain property of the recipient
• No requirement to revenue share upon successful commercialisation
Awards shall cover 100% of the direct costs of the project, provided such costs are Permitted Expenditure.
Permitted Expenditure is expenditure which is reasonably incurred and properly evidenced and is directly related to and necessary for the delivery of the Project. Typically, this will cover:
• An appropriate %FTE of staff, plus consumables, directly related to funded work
• Access to specialist equipment/reagents
• Contract Research Organisation work
• Reasonable travel and subsistence
Receipt of funding will be linked to achieving milestones and standard payment terms will be quarterly in arrears

Dr Tanja Taylor

• EOI Opens 1st Oct 2025
• Applicants apply online
• Queries can be submitted via webform
• EOI closes at 23:59 GMT on 5th Nov 2025
• Internal review by PACE team to select proposals to progress to full application
• Successful applicants invited to Catalyser workshop
• Sign Confidentiality Agreements
• Catalyser workshop forApplicants Jan 2026
• Full application developed with support from PACE team
• Application deadline: 27th March
• Due diligence conducted on applications by PACE team
• Review of applications by expert panel and patient representatives.
• Rebuttal to questions
• Applicants notified of outcome Project initiation
• Finalise project plans based on panel feedback
• Finalise budget and resource requirements
• ProjectAward agreements issued
• Project launch
Oct 2025
Nov 25 – Jan 26
Jan - Mar 2026 Apr - Jun 2026
Projects to start within 3 months from receipt of award letters

• Name, affiliations of lead applicant and any co-applicant(s)
• Application summary: Title, funding requested, duration, category e.g. therapeutic approach, modality, indication, pathogen and phase
• Project summary (max 500 words)
• Alignment to clinical need
• Novelty of approach
• Scientific rationale & supporting evidence (max 400 words) - includes option for 1 file upload
• Research plan – key research objectives, work packages, milestones and deliverables (max 1500 words)
• Relevant investigator/ collaborator expertise and experience for project delivery
• Gaps in current resources or capabilities that PACE could advise on or support to improve the impact of the proposed project
• Translational / commercialisation plan (max 300 words)
To be considered as a participant on the programme your expression of interest must be submitted between 1st October and 23:59 GMT on 5th November 2025 via the online portal


• Project summary
Summary
• Provide a summary of the approach, including target indication and pathogen(s), modality of intervention and key aims for the project.
Clinical positioning
• Explain how the intervention addresses the clinical need, including setting, target patient population(s) and any diagnostic, biomarker or stratification strategies to identify those.
• Would the proposed intervention likely be acceptable to patients (consider treatment burden)? What would be the expected impact on patient outcomes?
• How would the intervention be integrated into the current care pathway (e.g. in addition to or replacing current therapy, what diagnostics may be required and are these widely accessible and available)?
Novelty & competitive positioning
• Describe whether the approach is exploring a novel MoA, new target or new chemical class (with no observed cross resistance).
• Is the proposal differentiated from current standard of care, as well as from similar approaches (e.g. approaches with a similar target or mechanism) in development?

• Scientific rationale & supporting evidence
• How is modulation of the target linked to the desired anti-bacterial phenotypic effect (e.g. inhibition of an essential target for bacterial survival, reduction of bacterial virulence, directing host immune response)?
• Is there sufficient evidence (in vitro, in vivo) to support: mechanism, therapeutic effect in relevant strains & models, safety, low propensity for resistance development etc?
• Research plan
• Is the plan feasible within the given timeframe, budget and resource as well as appropriate for the development stage? Does the team have access to all required expertise, tools and resource to deliver the plan or reasonable plans to obtain those?
• Are milestones clearly defined, realistic, time-bound and measurable?
• Will the outputs progress the project towards a value inflection point to secure onward funding?
• Translation/ Exploitation plan
• Does the team have access to any required background IP or plans for obtaining access to required IP?
• Does the team have a reasonable IP and commercialisation strategy?
• Have the team got credible plans for onward progression and funding of the project (e.g. engagement of downstream funders/ investors/ partners/ regulators)
• Have potential barriers to patient benefit been identified and how will they be addressed?

Dr Pete Coombs
• Every application is required to have a clearly articulated target profile outlining the target indication(s), use and drug profile.
• These should demonstrate consideration for patient and clinical needs, as well as key drug characteristics such as:
• Organism coverage
• Patient population
• Treatment duration and frequency
• Route of administration
• In vitro and in vivo activity data
• Safety and tolerability
• Cost and value proposition


• Priority will be given to solutions for indications associated with the highest burden of AMR and tackling MDR pathogens.
• Examples of TPPs include those developed by WHO, CARB-X and CF AMR Syndicate.
Target product profile for therapy of severe infections caused by multidrug resistant Gram-negative bacteria


WHO Draft Target Product Profiles for new antibacterial agents

• The project should be sufficiently novel –defined by WHO novelty criteria: novel MoA, new target, new chemical class, no observed cross resistance

Clinical positioning
• The project aligns against a clearly defined clinical unmet need
• A credible clinical path to approval and clinical use
• The project aligns to an established or has a draft TPP
Scientific rationale & supporting evidence
• Evidence that target/ pathway modulation is linked to desired phenotype in relevant pathogens aligned with call scope e.g. MICs (ideally activity against drug resistant strains demonstrated)
• Evidence/ rationale for low propensity for resistance
• Evidence/ rationale for target engagement and bacterial permeability
• Evidence/ rationale for de-risking off-target activity, toxicity (dependent on entry stage)
• Data from relevant activities/ assays appropriate for the stage of the project (e.g., hit-to-lead versus LO)
Project plan & resources
• The project plan is credible given the timeframe and budget
• Appropriate milestones have been set
• The deliverables position the project well for onward funding
• Additional required resources/ expertise for the project delivery are highlighted and are accessible
• Applicants own or have access to relevant background IP
• IP strategy is established
• Competing IP/ FTO considerations are addressed
• Consideration of onward funding, clinical progression and business plan

• Milestones - a specific point in time within a project plan that aligns to a critical go/ no-go point in which the results generated up until that point are critically evaluated to assess whether the project should continue. Milestones will have associated success criteria which will be agreed by PACE prior to award

Criteria Minimum Entry Requirements
• Inhibition of defined target in at least one relevant assay
Potency & SAR
In vitro ADMET
• Indication of early, understandable SAR
Microbiology
In vivo
• Demonstration of cell-based mechanism of action in relevant target bacterial species (e.g. MIC for direct acting)
• Established SAR with clear optimization to improve on in vitro potency, chemical stability, cytotoxicity and drug-like physicochemical properties
• Selectivity against any relevant human targets
• Promising in vitro ADME properties (e.g. if oral route demonstration of potential oral bioavailability)
• Low or no cytotoxicity in relevant human cell lines
• Any significant liabilities understood with credible strategy to address these
• Significant cellular activity against TPP relevant pathogens (including MDR clinical isolates)
• Understanding of mechanism of action, target engagement, and potential permeability and efflux liabilities
• Significant SAR and chemical design across lead scaffold(s)
• Excellent selectivity against any relevant human targets
Other
• Active upon resynthesis, purity >90%
• Preliminary in vivo efficacy data (e.g. thigh infection model)
• Promising in vivo PK (associated with intended route of administration)
• Good microsomal, hepatocyte and plasma stability
• Acceptable plasma-protein binding
• Profiling in in vitro safety and secondary pharmacology assays (e.g. Cyp inhibition, hERG, nephrotox, CEREP)
• Improved potency in cellular activity against relevant pathogens in extended clinical isolate panels
• Frequency of resistance, mechanisms of resistance, killing kinetics, MIC90 measurements and confirmed understanding of mechanism of action
• in vivo efficacy data (associated with intended route of administration & disease-relevant models) against multiple pathogen isolates
• Experiments to understand PK-PD drivers
• Non-GLP toxicity study (MTD, repeat dosing) in suitable species
• Synthetic route amenable to scale-up to support LO, preclinical and IND enabling studies

Further questions –contact via website form
Terms and Conditions
Online EOI closes 23:59 GMT on 5 Nov
Please note – all applicants must complete the online EOI before 23.59 GMT on 5 Nov 2023 to be considered for this funding call


